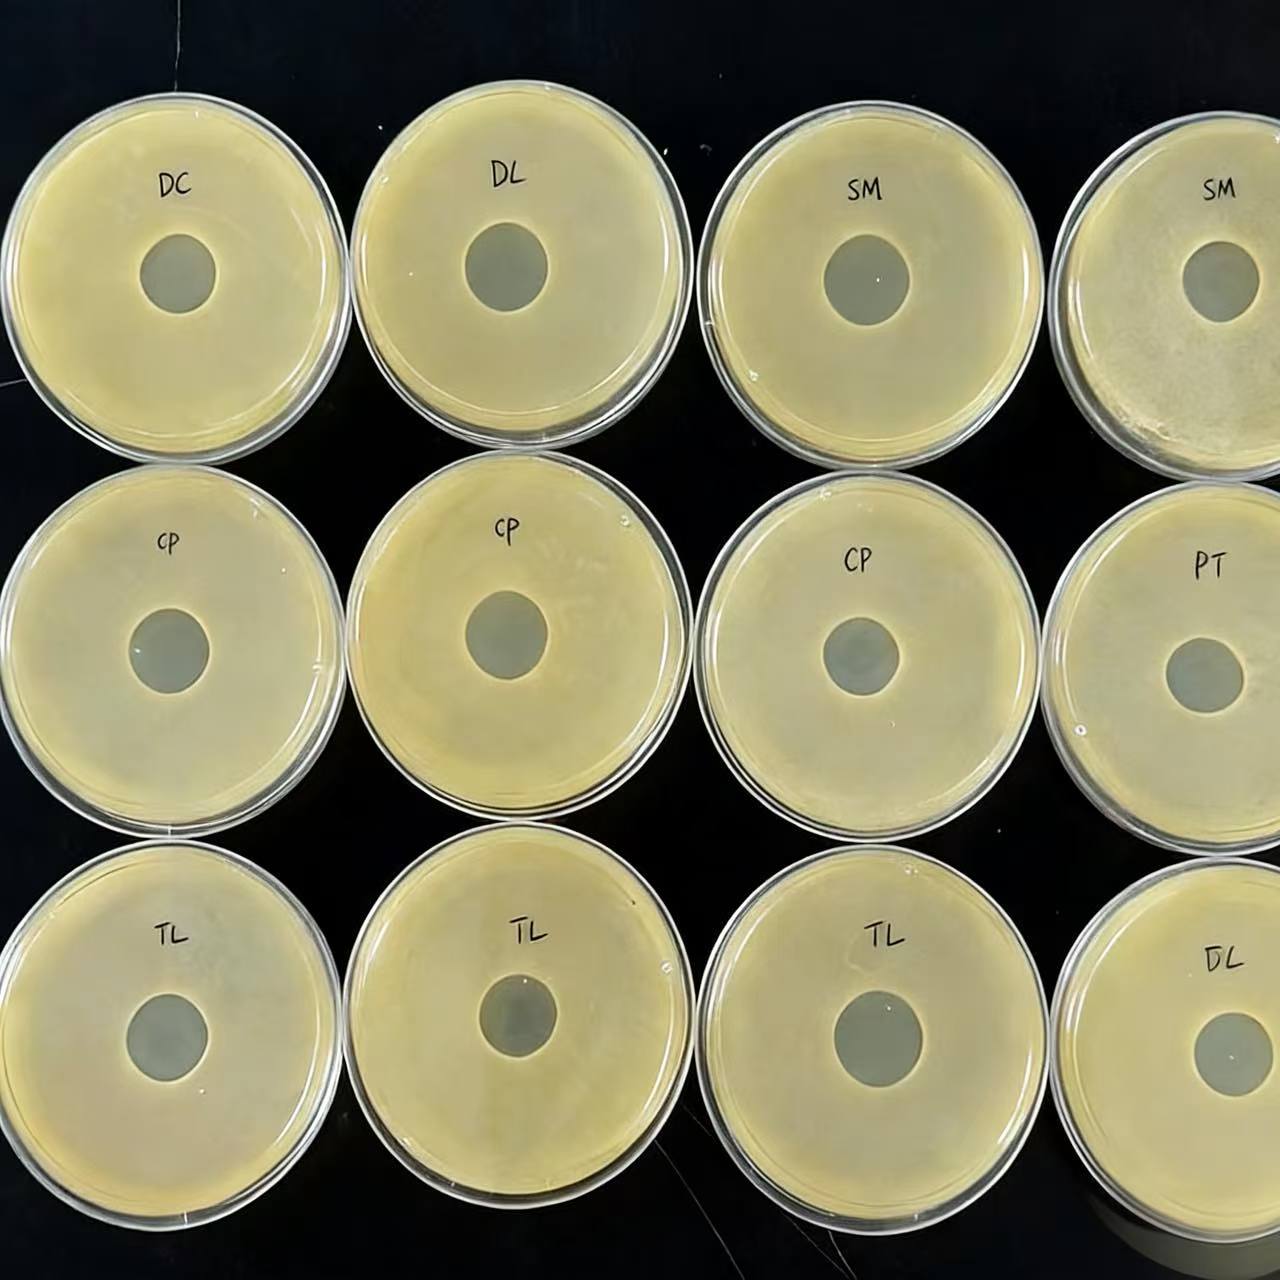
The lysis images of GEAIA 6000 against Escherichia coli, Salmonella, Staphylococcus and Clostridium perfringens in the experiment (2)

GEAIA 6000
Prevention and control of Escherichia coli spp Salmonella spp, Staphylococcus spp., Clostridium perfringens, Pseudomonas aeruginosa. in chickens
Prevention and control of Escherichia coli spp Salmonella spp, Staphylococcus spp., Clostridium perfringens, Pseudomonas aeruginosa. in chickens
GEAIA 6000 integrates the world’s advanced phage biotechnology, intestinal microecology research and practical breeding experience, providing global poultry producers with a high-end, comprehensive and intelligent solution for bacterial disease management and intestinal health regulation.
| Used for |
Poultry |
|---|---|
| Packaging |
20Kg/drum |
| Major Ingredient |
Phage lysin + Bacillus subtilis |
| Dosage and usage |
prevention and therapy : Feed additive dosage: 500 g/ton |
| Function |
Prevention and control of Escherichia coli spp Salmonella spp, Staphylococcus spp., Clostridium perfringens, Pseudomonas aeruginosa. in chickens |
| Temperature Tolerance Range |
0-120°C |
| Shelf Life |
24 months at 30°C |
| Apperance |
Powder |
| Precautions |
Please do not use this product with disinfectants together |

Reviews
Clear filtersThere are no reviews yet.